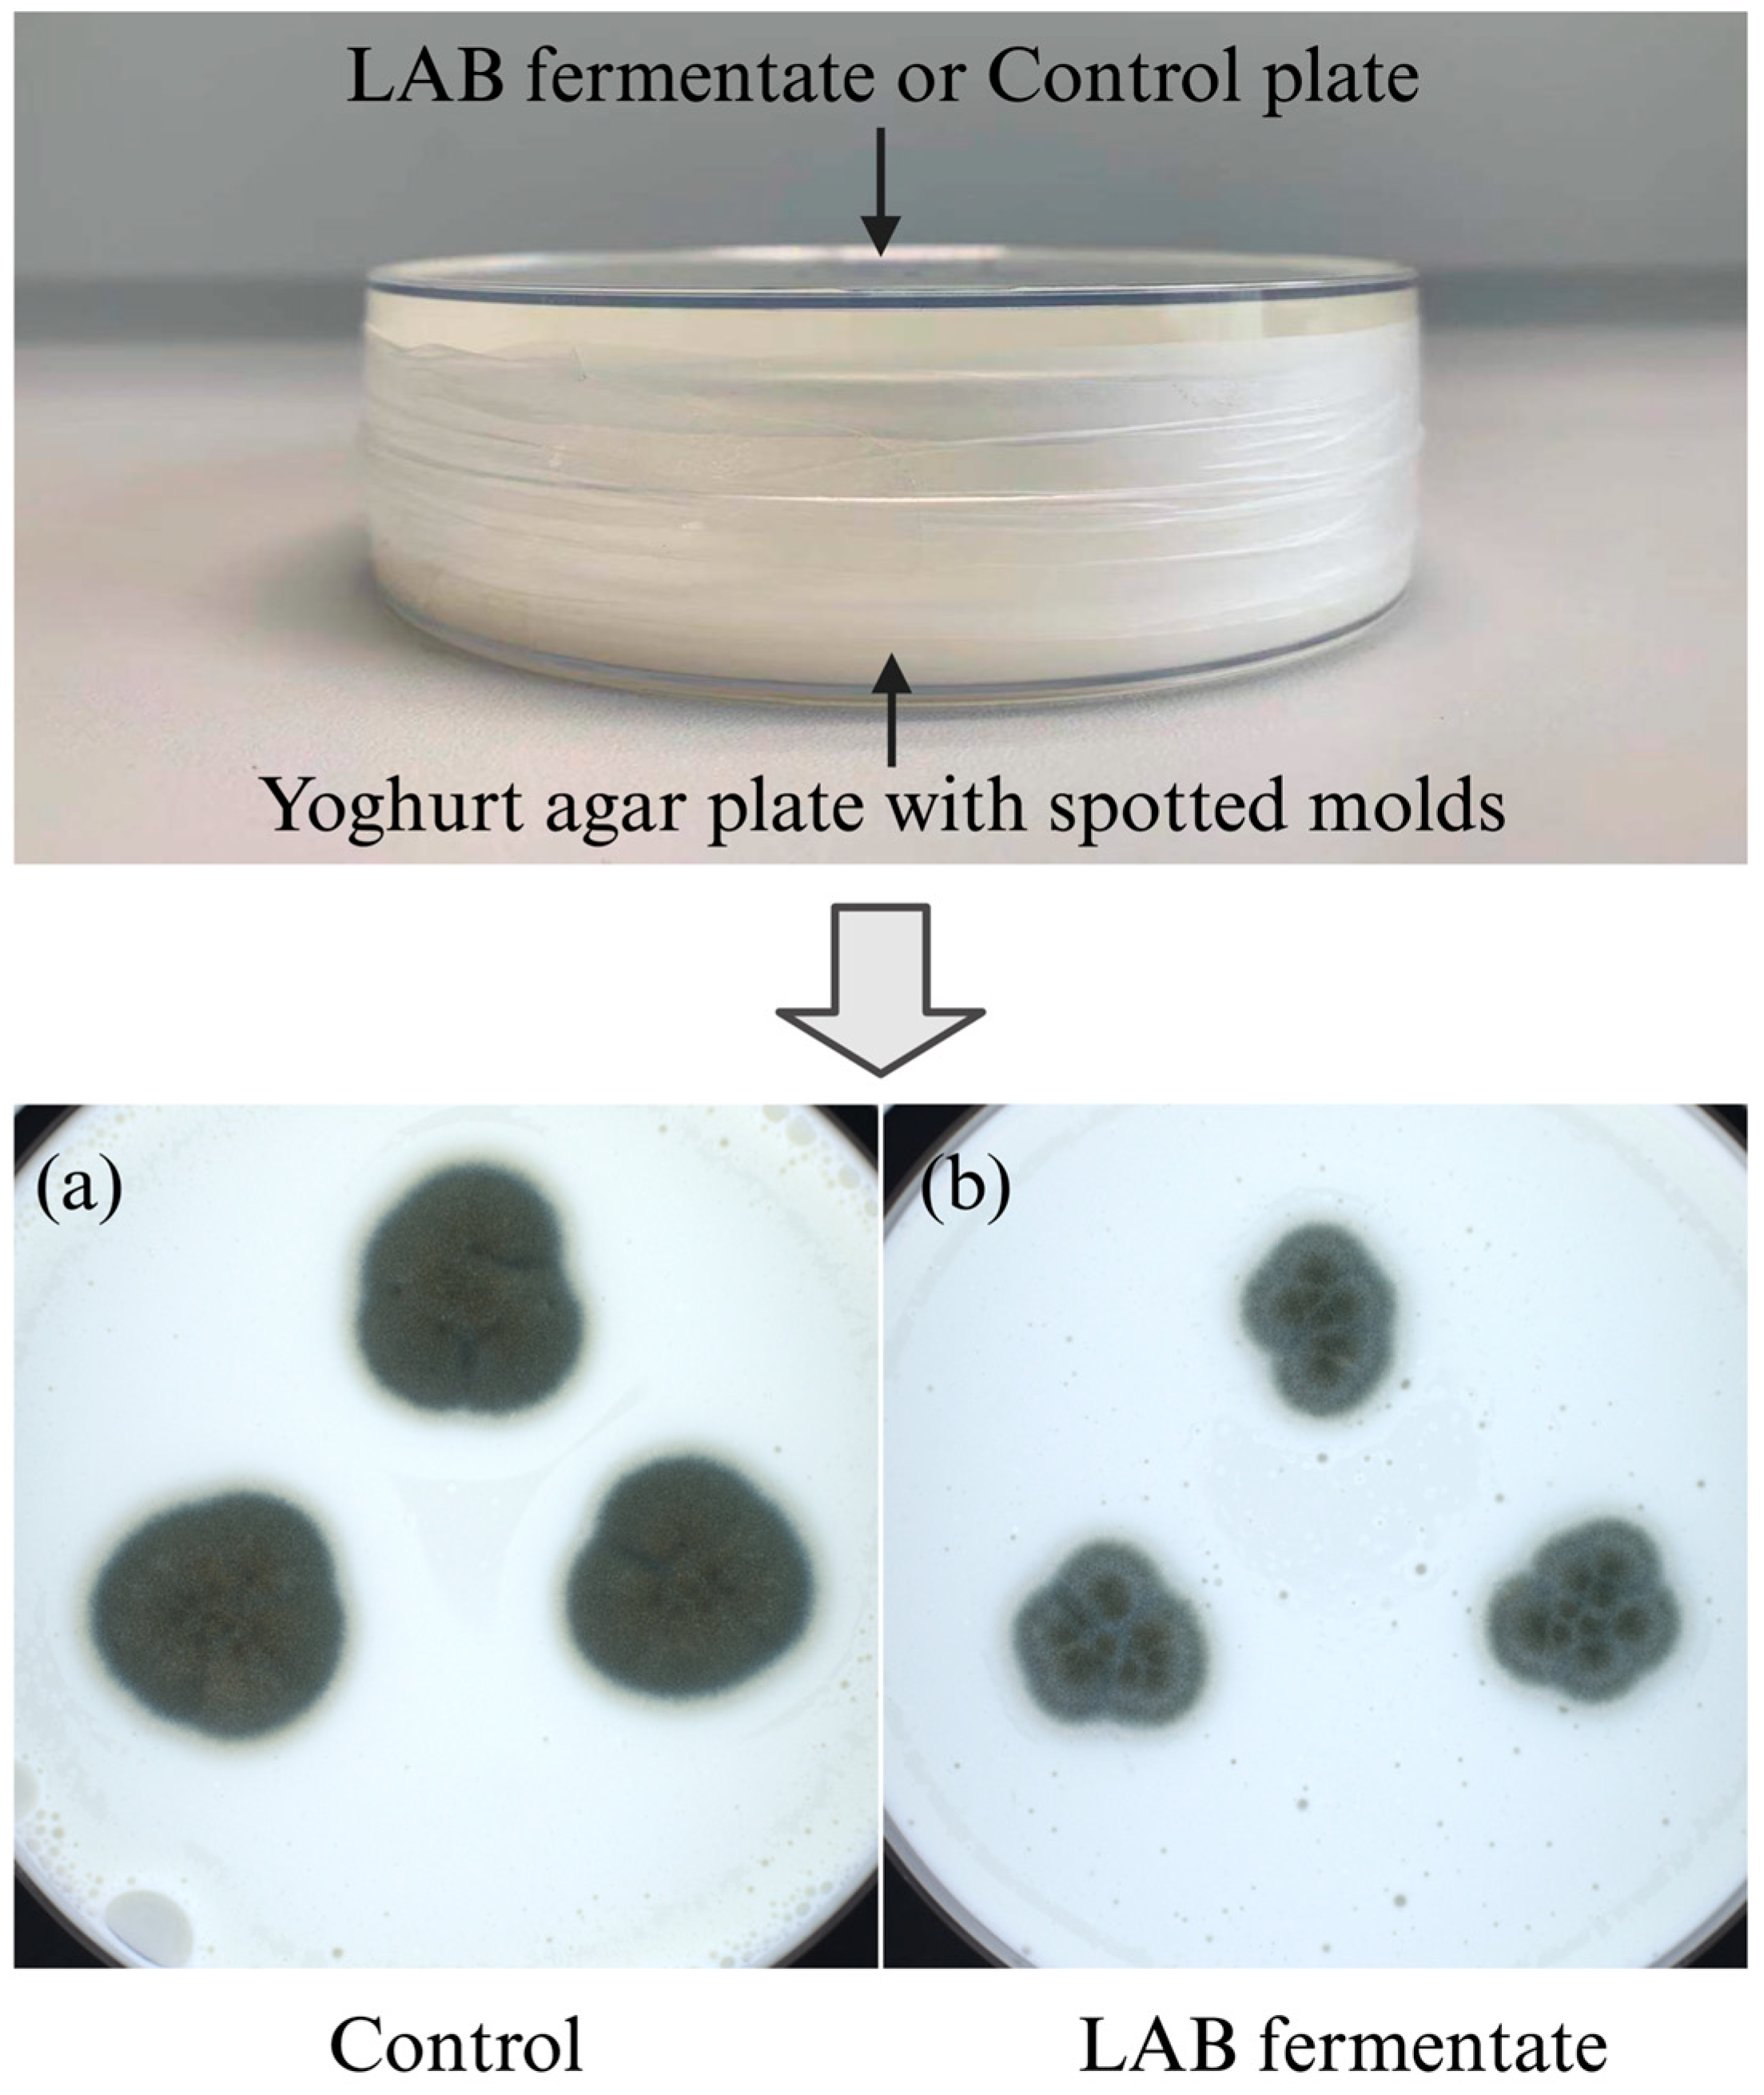
Molecules 28 07397 g003

Abstract
Penicillium spp. are considered a major spoilage fungus in dairy products. Due to the growing concerns over food safety issues and the demand for “clean label” food products from consumers, the use of lactic acid bacteria (LAB) as a bioprotective tool to control fungal spoilage of dairy products appears to be a promising alternative. Here, the antifungal activities of ten LAB cultures against five dairy-spoilage-associated Penicillium strains were studied in a model system, and the most potent bioprotective cultures were further tested in yoghurt. Lacticaseibacillus rhamnosus (L. rhamnosus) LRH01 and Lactiplantibacillus plantarum (L. plantarum) LP01 exhibited potent antifungal efficacy at low concentrations. The inhibitory effects of cell-containing fermentates (C-fermentates), cell-free fermentates (CF-fermentates), and volatiles produced by the two cultures were tested in a yoghurt serum medium. The C-fermentates showed antifungal effects, while the removal of cells from C-fermentates led to decreased antifungal activities. Volatiles alone displayed some antifungal efficiency, but less than the fermentates. In a yoghurt matrix, the specific effect of manganese depletion by the bioprotective cultures on mold growth was investigated. Here, the LAB cultures could completely suppress the growth of molds, while addition of manganese partially or fully restored the mold growth, demonstrating that manganese depletion played a key role in the antifungal activity of the tested LAB cultures in the yoghurt matrix. Both L. plantarum LP01 and L. rhamnosus LRH01 showed efficient antifungal activities in the yoghurt serum, while L. rhamnosus LRH01 exhibited the most potent inhibitory effects on Penicillium strains when added during the processing of the yoghurt with subsequent storage at 7 °C for 22 days. Our findings suggested that L. rhamnosus LRH01 could be a promising bioprotective culture for yoghurt biopreservation.
1. Introduction
Fermented dairy products such as yoghurt are of high economic importance. Although yoghurt is generally considered to be microbiologically stable, it may be subjected to contaminations with acid-resistant spoilage fungi at the processing site as well as by the consumers. Penicillium is the most frequently and abundantly isolated genus among the dairy-associated spoilage molds, including species such as Penicillium roqueforti (P. roqueforti), Penicillium glabrum (P. glabrum), and Penicillium commune (P. commune) [1,2,3,4]. Mold spoilage represents a significant factor that may impact the stability and commercial value of dairy products, and spoilage not only leads to substantial food waste and economic losses worldwide but may also result in adverse effects on human health due to mycotoxin production in some cases [2]. To avoid mold problems in the dairy industry, an extensive range of hurdle technologies have been used, including chemical preservatives such as sodium benzoate, potassium sorbate, and potassium benzoate [5]. With increasing fungal resistance to these chemical preservatives and the growing demand for natural, less processed, healthy, or preservative-free “clean label” food products, the use of bioprotective cultures as a promising alternative to control unwanted organisms, and thus extend food shelf life, has attracted much attention in recent years [6,7].
Many lactic acid bacteria (LAB) species are regarded as obvious candidates for bioprotection due to a long history of safe use as indicated by their GRAS (Generally Recognized as Safe) status [8] and inclusion in the “Qualified Presumption of Safety” (QPS) list in Europe [9,10]. In addition, several LAB cultures, including Lactiplantibacillus plantarum (L. plantarum), Lacticaseibacillus rhamnosus (L. rhamnosus), and Lacticaseibacillus casei strains, have been observed to display antifungal activity, thereby potentially extending the shelf life of dairy products [6,9,11]. It was, for example, recently found that the growth of P. commune was inhibited by L. plantarum 885, 897, and 299v, indicating that these L. plantarum cultures could be promising candidates for the biopreservation of Cheddar cheese [12]; another study discovered that L. rhamnosus exhibited a strong inhibitory effect on fungal growth on semi-hard cheese after 6 weeks of ripening at 10 °C [13].
Concerning the antifungal mode of action, considerable efforts have been devoted to elucidating the mechanisms behind the antifungal potential of LAB. Numerous metabolites identified from LAB cultures have been seen to exhibit antifungal activities, such as organic acids including lactic acid and acetic acid, fatty acids, proteinaceous compounds including bacteriocins and bacteriocin-like substances, and other compounds with low or medium molecular weight mass including volatiles, such as diacetyl [14]. It has, however, been noticed that the concentrations of these antifungal metabolites produced by LAB cultures in situ have typically been significantly lower than their corresponding minimal inhibitory concentrations (MICs) [15]. Other antifungal mechanisms have therefore been investigated, and more recently, competitive exclusion through manganese depletion was uncovered as the main antifungal mechanism behind the antifungal activity of the L. paracasei and an L. rhamnosus strains in yoghurt [16]. The addition of manganese with increasing concentrations (up to 6 mg/L) positively correlated with the mold and yeast growth. Our previous study also demonstrated that 0.001–0.1 mM of manganese supplementation could partially or fully restore the growth of Penicillium and Mucor strains, otherwise inhibited by L. plantarum LP37 [17].
The aim of the current study is to test the bioprotective potential of several cultures against a panel of five common dairy-spoilage-associated Penicillium strains, and investigate the contributing role of LAB fermentates and volatiles to the antifungal activity in a model system as well as the specific role of manganese depletion in a yoghurt matrix and finally in a challenge test in order to determine their potential as bioprotective cultures for yoghurt.
2. Results
2.1. Antifungal Potential Evaluation
The antifungal potential of the ten LAB cultures against the five dairy-spoilage-associated Penicillium strains (Table 1) is shown in Figure 1. All the LAB cultures were active against the tested molds, producing a clear inhibition zone area, although large variations were observed after incubation at 25 °C for 3 days. In general, L. rhamnosus and L. plantarum seemed more effective at inhibiting mold growth compared with the L. paracasei cultures (L. paracasei LPC44 and L. paracasei LPC46). In particular, L. rhamnosus LRH01, L. plantarum LP01, and L. plantarum LP37 at 107 CFU/mL exhibited stronger antifungal activity against the Penicillium strains, while L. plantarum LP48 and two L. paracasei strains were less active. With regards to the target organisms, the Penicillium strains displayed various degrees of sensitivity towards the LAB cultures with P. glabrum ISI3 and P. palitans PPa01 being more sensitive, and P. crustosum 01180001 and P. solitum ISI5 more resistant to the LAB cultures.
Table 1.
Ten LAB strains and five dairy spoilage-associated Penicillium strains used in this study.
Figure 1.
Antifungal potential of ten LAB cultures (107 CFU/mL) on MRS agar overlaid with a suspension of five Penicillium strains. Results were expressed as the inhibition zone area (number in pixels). The values represent mean ± SD. Images showed the inhibition zones of L. rhamnosus LRH01 (A) and L. plantarum LP01 (B) against each mold after incubation for 3 days at 25 °C, respectively. LRH01, LRH05, LRH14, LRH16, and LRH43 were L. rhamnosus strains; LP01, LP37, and LP48 were L. plantarum strains; LPC44 and LPC46 were L. paracasei strains.
2.2. Minimal Inoculum Levels of LAB Cultures to Achieve Fungal Inhibition
After incubation at 25 °C for 3 days, the growth of all the tested molds was strongly inhibited by these LAB cultures at high inoculum levels such as 107 CFU/mL (Table 2). However, large variations in the antifungal potential were observed, with the minimal inoculum levels ranging from 104 to 107 CFU/mL. Two out of the ten LAB cultures presented efficient growth-inhibitory effects, in some cases at concentrations down to 104 CFU/mL, namely L. rhamnosus LRH01 and L. plantarum LP01. For example, the growth of P. glabrum ISI3, P. solitum ISI5, and P. palitans PPa01 was inhibited by L. rhamnosus LRH01 at 104 CFU/mL, and L. plantarum LP01 at 104 CFU/mL suppressed the growth of P. solitum ISI5, P. palitans PPa01, and P. crustosum 01180001. In contrast, the minimal inoculum levels of L. plantarum LP48 and L. paracasei LPC46 against all the tested molds were 107 CFU/mL, demonstrating that higher concentrations of these cultures were required to completely inhibit fungal growth. After incubation for 5 days, the mold growth was still inhibited by the LAB cultures at 107 CFU/mL. In general, when concentrations below 107 CFU/mL were applied, the effect on mold growth decreased significantly or even disappeared, illustrating that although some LAB cultures could suppress mold growth at a low concentration, a higher concentration (e.g., 107 CFU/mL) was required to achieve extended inhibitory action.
Table 2.
Minimal inoculum levels (CFU/mL) of ten LAB cultures to achieve growth inhibition of five Penicillium strains after incubation in MRS medium for 3 days at 25 °C.
Based on the above results, L. rhamnosus LRH01 and L. plantarum LP01 were selected for the following experiments due to their efficient antifungal activities.
2.3. Antifungal Activity of Selected LAB Cultures in Yoghurt Serum
2.3.1. Interaction of Penicillium Strains and C-Fermentates with Live Cells
To evaluate the contribution of LAB metabolites to the overall antifungal activity of these LAB cultures, the inhibitory effects of cell-containing fermentates (C-fermentates), cell-free fermentates (CF-fermentates), and the volatiles on the growth of five Penicillium strains were tested. Moreover, yoghurt serum was prepared as a yoghurt-mimicking model to replace the laboratory medium. Results in this test showed that the C-fermentates of L. rhamnosus LRH01 and L. plantarum LP01 in yoghurt serum exhibited potent antifungal activities against the five Penicillium strains, with the inhibitory effects ranging from 83% to 92% after incubation for 5 days at 25 °C, respectively (Figure 2A). Among the five Penicillium strains, the P. glabrum ISI3 and P. palitans PPa01 were more sensitive towards the C-fermentates of L. rhamnosus LRH01 and L. plantarum LP01 with inhibitory effects up to 90%. P. commune ISI2 was less sensitive to the C-fermentate of L. rhamnosus LRH01, the inhibitory effects were around 83%, followed by P. crustosum 01180001 and P. solitum ISI5. In the case of L. plantarum LP01, P. solitum ISI5 was less sensitive to the C-fermentate.
Figure 2.
Inhibitory effects (%) of C-fermentates (A), CF-fermentates (B), and volatiles (C), respectively, produced by L. plantarum LP01 and L. rhamnosus LRH01 in yoghurt serum against five Penicillium strains. Control groups were prepared by spotting each mold suspension on the plates prepared by mixing un-inoculated MRS broth with agar. Error bars represent the standard error of the mean of three replicates.
2.3.2. CF-Fermentates
The antifungal activities of CF-fermentates of L. rhamnosus LRH01 and L. plantarum LP01 are shown in Figure 2B. Although the inhibitory effects significantly decreased after removal of cells from C-fermentates of the two cultures, large variations in mold-growth inhibition were still observed. In general, the inhibitory effects of the two CF-fermentates on the five Penicillium strains ranged from 26% to 59%. In comparison with L. rhamnosus LRH01, the CF-fermentate of L. plantarum LP01 exhibited more potent antifungal effects. The inhibition could be due to both the preformed metabolites produced by the LAB cultures in the yoghurt and/or a depletion of the limiting nutrients or trace elements by the LAB cultures [17].
2.3.3. Contribution of Volatiles to the Antifungal Activity
To test the antifungal effects of the volatiles produced by LAB cultures, a plate-on-plate system was employed in this assay (Figure 3). Compared with the LAB fermentates with or without live cells, the inhibitory effects of volatiles produced by L. rhamnosus LRH01 or L. plantarum LP01 were much weaker (Figure 2C), ranging from 4% to 31%. Generally, volatiles from L. plantarum LP01 showed stronger inhibitory effects compared with those from L. rhamnosus LRH01. P. commune ISI2 only responded weakly to both LAB cultures, indicating low susceptibility to the volatiles, while P. palitans PPa01, on the other hand, was relatively sensitive. These data here were consistent with the results of the C-fermentate test. In summary, the results suggest that the volatiles produced by L. rhamnosus LRH01 and L. plantarum LP01 contribute, but only to a limited extent, to the overall antifungal activity.
Figure 3.
An example of “Plate-on-Plate” system. Influence of volatiles produced by L. rhamnosus LRH01 fermentate (top plate) on the growth of P. commune ISI2 spotted in triplicates on a yoghurt plate (bottom plate). Growth of mold on bottom yoghurt agar plate with either a non-inoculated control plate (yoghurt serum agar plate) on top (a) or a LAB inoculated agar plate on top (b).
2.4. Effect of Manganese on the Antifungal Activity
Here, a commercial plain yoghurt was used as a matrix to ensure a realistic manganese level. The Penicillium strains showed various levels of sensitivity when grown with L. plantarum LP01 or L. rhamnosus LRH01 on yoghurt-agar plates with or without manganese (Figure 4A). In comparison to the control groups, the growth of the five Penicillium strains was markedly inhibited by both L. plantarum LP01 and L. rhamnosus LRH01 in yoghurt. However, mold growth was partially or fully restored when manganese was added in increasing concentrations from 0.001 mM to 0.1 mM. For example, P. crustosum 01180001 growth was completely inhibited by L. plantarum LP01 in yoghurt, but the addition of manganese at 0.1 mM resulted in fully restored mold growth (Figure 4B). Although supplementation of manganese also restored the mold growth in yoghurt prepared with L. rhamnosus LRH01, it is worth noting that, in comparison to L. plantarum LP01, the L. rhamnosus LRH01 seemed more efficient at removing manganese since higher amounts of manganese were required to restore mold growth, especially in the case of P. solitum ISI5 and P. palitans PPa01 where growth could not be restored even after 0.01 mM manganese was added. In the case of L. plantarum LP01, the growth of most tested molds could be partially restored when 0.001 mM of manganese was added, while in the case of L. rhamnosus LRH01, 0.01 mM of manganese was required.
Figure 4.
(A) Changes in mold colony size (number in pixels) on the yoghurt agar plates with different Mn levels. The values were expressed as the mean values of three replicates. (B) Images of mold growth on yoghurt plates showing L. plantarum LP01 and P. crustosum 01180001 as example. Manganese in different concentrations was added as indicated. The spoilage molds were added in concentrations of 200 spores/spot. The plates were incubated at 25 °C for 5 days. LP01 and LRH01 indicates L. plantarum LP01 and L. rhamnosus LRH01, respectively.
2.5. Challenge Test in Yoghurt
The challenge test was carried out by simulating the expected processing and storage conditions more closely, using yoghurt produced with the test strains added together with the starter cultures and simulating surface contamination of the finished yoghurt during storage at 7 °C. Here, L. rhamnosus LRH01 exhibited strong antifungal activity against the five tested Penicillium strains in yoghurt. The negative control groups without bioprotective cultures showed visible growth of these Penicillium strains after 9–13 days. The yoghurt samples with L. rhamnosus LRH01, however, delayed growth of the five Penicillium strains for a further 12–18 days, while L. plantarum LP01 delayed the mold growth for only 1–2 days (Figure 5A). As shown in Figure 5B, after incubation for 22 days at 7 °C, all the negative control groups were overgrown with the target molds, while there was almost no visible mold growth in the yoghurt samples inoculated with L. rhamnosus LRH01. In contrast, although mold growth was partly inhibited by L. plantarum LP01 in comparison with yoghurt without added test cultures, the L. plantarum LP01 in yoghurt did not exhibit a similar efficacy as seen previously in MRS medium.
Figure 5.
(A) Days of visible mold growth delay caused by L. rhamnosus LRH01, L. plantarum LP01, and LR4PD (positive control). Wells with indicator molds but without either L. rhamnosus LRH01 or L. plantarum LP01 served as negative controls. The values were expressed as the mean values of three replicates. Significant statistical differences compared with the control group were all at **** p < 0.0001. (B) Images of yoghurt with spotted molds after incubation for 22 days at 7 °C.
3. Discussion
In the present study, LAB cultures with potent antifungal activities against five dairy-associated Penicillium strains were first screened out in laboratory media. Subsequently, the relative role of actively growing cells versus bioactive metabolites was investigated in a yoghurt serum matrix, and the role of manganese competitive exclusion in the antifungal effect was tested in plain yoghurt. Finally, selected LAB cultures were used as bioprotective cultures in a challenge test. At first, two methods were used to screen the most efficient mold inhibitory LAB cultures in MRS medium: an assessment of the antifungal potential at the same LAB inoculum level (107 CFU/mL) and an evaluation of the minimal inoculum levels needed for inhibition. At 107 CFU/mL, the most efficient strains belong to the species of L. rhamnosus and L. plantarum, and, in particular, to the strains of L. rhamnosus LRH01, L. rhamnosus LRH16, L. plantarum 01, and L. plantarum 37. Several L. plantarum as well as L. rhamnosus strains have also been found to have inhibitory effects on fungal growth in previous studies [9,12,13,18]. All ten LAB cultures exhibited inhibitory effects against dairy-associated spoilage molds, but the inhibitory efficacy is highly strain dependent. Among the tested strains here, L. rhamnosus LRH01 and L. plantarum 01 showed the most potent antifungal activity at low concentrations (104 CFU/mL). Therefore, L. rhamnosus LRH01 and L. plantarum 01 were selected for the further investigations.
Several previous studies have looked at the antifungal metabolites produced by LAB in the supernatant [18,19,20,21,22]. In order to investigate the role of antifungal metabolites in the antifungal effects of LAB cultures during inhibition in a yoghurt scenario, the sensitivity of the five Penicillium strains towards LAB fermentates with or without live cells in yoghurt serum, and towards volatiles, was explored. As expected, the fermentates with live cells of L. rhamnosus LRH01 and L. plantarum 01 significantly inhibited Penicillium strains growth. However, the inhibitory effect decreased after the removal of the live cells from the fermentates, indicating that the presence of live cells in the fermentates increased the inhibitory effects. A recent review summarized many of the compounds associated with antifungal effects including organic acids, short- and long-chain fatty acids such as 3-phenyllactic acid, 4-hydroxyphenyllactic acid, and indole-lactic acid, as well as proteinaceous compounds such as bacteriocins. In most cases, the inhibition assays have been conducted in model systems [23]. In addition, the contribution of volatiles produced by LAB cultures to the antifungal activity has been reported in recent years. Volatile compounds, including acetic acid responsible of the antifungal activity, were identified from L. plantarum cultures [24] and it has previously been highlighted that the main volatile compound produced by L. paracasei DGCC 2132 is diacetyl, which exhibited antifungal activity against P. solitum DCS 302 and Penicillium sp. nov. DCS 1541 [14]. In addition, the specific effect of diacetyl against P. commune and P. crustosum in yoghurt has been reported. The MIC was 32 μg/mL, and the antifungal mechanism was related to the integrity of the cell membrane and oxidative stress [25]. Recently, the application of volatile compounds produced by LAB cultures has been mentioned as a promising strategy for the prevention and control of fungal contamination in food products. A volatile compound, 1-pentanal, produced by a Lactobacillus curvatus strain showed excellent inhibition against A. flavus in red pepper powder, indicating that this volatile could be a promising biopreservative agent to prevent fungal contamination [26]. In the present study, however, volatiles produced by L. plantarum LP01 and L. rhamnosus LRH01 in yoghurt serum were only moderately effective in suppressing the growth of Penicillium strains, indicating that volatiles alone were a contributing but not a main factor in this system.
Competitive exclusion through manganese depletion was recently found to be the main mechanism in several LAB cultures for restraining the growth of spoilage fungi [16]. Manganese is an essential component in a variety of enzymes with physiological functions and acts as a cofactor in some metalloenzymes [27,28,29]. In the current study, it was found that manganese played a key role in the antifungal activity of the tested LAB cultures in a yoghurt matrix since the addition of manganese could restore mold growth in a concentration-dependent manner. More manganese was required in the case of L. rhamnosus LRH01 than was seen for L. plantarum LP01. For L. plantarum LP01, the addition of 0.001 mM of manganese in the treatment group could restore the mold growth of e.g., P. solitum ISI5, while 0.1 mM of manganese was required to restore mold growth in the case of L. rhamnosus LRH01. Therefore, L. rhamnosus LRH01 supposedly possesses a stronger manganese depletion capacity in comparison with L. plantarum 01, resulting in a more potent antifungal activity in yoghurt. LAB have been shown to be able to take up the manganese in an environment or culture medium through two major uptake systems which are composed of the Natural Resistance-Associated Macrophage Protein (NRAMP)-type transporter MntH (under acidic conditions) and the ABC-type transporter SitABC (mainly active at neutral pH) [30]. Recently, manganese transporter genes (mnth1, mnt2, and mnt3) and the manganese transport operon mntr, were identified in L. plantarum CCFM436, and MntH 1–3, were speculated to be the potential manganese importers which were negatively regulated by MntR [31]. Similar research also reported that the expression of the manganese transporter, MntH1, encoded by the mnth1 gene, was significantly higher in L. rhamnosus and L. paracasei, facilitating the exhaustive manganese removal in fermented milk [16]. Further studies should be performed to evaluate the manganese transporter system of potential bioprotective cultures in products with different matrix properties, oxygen availability, and pH and at different temperatures.
To validate the application of L. rhamnosus LRH01 and L. plantarum LP01 as bioprotective cultures in dairy products, a challenge test was conducted in yoghurt where the strains had been added during production. Here, L. rhamnosus LRH01 caused a significant visible mold growth delay at 7 °C, while there was very limited mold growth delay observed in the case of L. plantarum LP01. Furthermore, L. rhamnosus LRH01 still displayed antifungal activity in yoghurt after incubation for 22 days, which was in line with the results in the positive control group. These results demonstrated that L. rhamnosus LRH01 could be a promising bioprotective culture in yoghurt production. It is worth noting that L. plantarum 01 exhibited stronger inhibitory effects on the Penicillium strains when the test with the yoghurt serum took place at an elevated room temperature, while in yoghurt, where the strains were part of both the fermentation and the later chill storage, the L. rhamnosus LRH01 showed a more potent inhibition. It is possible that these differences partly reflect how well these cultures are adapted to the temperatures encountered both during fermentation and later during storage since growth rates and metabolic activity may differ [2]. It therefore adds to the complexity of predicting mold sensitivity and efficacy of bioprotective cultures that impact factors such as matrix composition including manganese content and storage temperature should be taken into account.
4. Materials and Methods
4.1. Organisms and Chemicals
The frozen stock cultures of the 10 LAB cultures used in this study (Table 1) were stored at −80 °C in De Man, Rogosa, and Sharpe (MRS) broth with the addition of 20% glycerol. The LR4PD, composed of L. rhamnosus strains (commercial culture Lyofast supplied by Sacco S.r.l, Cadorago, Italy), was used as the positive control in the yoghurt challenge test. Five Penicillium strains used as indicator molds were isolated from freshly fermented dairy products (Table 1). Malt extract agar plates (MEA, pH 5.6 ± 0.2) prepared using 30 g/L malt extract, 5 g/L peptone, and 15 g/L agar were used as culture medium for mold growth at 25 °C for 7 days, and then the spore suspension of each mold was collected by centrifugation in malt extract broth (MEB, 17 g/L malt extract, 3 g/L peptone, pH 5.6 ± 0.2), and counted with a Malassez counting chamber. The suspension concentration of each mold was adjusted to 1.0 × 106 spores/mL and subsequently stored at −80 °C for further use. Malt extract, peptone, and agar were obtained from Thermo Fisher Scientific Inc. (New York, NY, USA). Manganese chloride (MnCl2), purchased from Sigma-Aldrich (Schnelldorf, Germany), was used in the manganese depletion test. The commercial plain yoghurt (0.5% fat, Arla Foods, Viby, Demark) was obtained from the local supermarket (Copenhagen, Denmark).
4.2. Antifungal Activity of LAB Cultures
The antifungal effects of the ten LAB cultures against the Penicillium strains were determined based on the overlay method with some modifications [13]. In brief, five microliters of each LAB culture (107 CFU/mL) were spotted on MRS agar in triplicate, and then anaerobically incubated at 37 °C for 48 h. The plates (diameter: 94 mm) were then overlaid with 8 mL of malt extract soft agar (0.5% agar), inoculated with each mold spore suspension (the final concentration was approximately 104 spores/plate), and incubated at 25 °C for 3 days until an even layer of mold was visible. Multispectral images of the plates were captured using a Videometer Lab2 spectral imaging instrument after incubation. The MATLAB 2018b software (MathWorks, Inc., Natick, MA, USA) was utilized to quantify mold growth based on colony size (total number of pixels) [32]. The area (number of pixels) values were then calculated according to the formula:
4.3. Determination of Minimal Inoculum Levels of LAB Cultures to Achieve Fungal Inhibition
The minimal inoculum levels needed for the 10 LAB cultures to achieve fungal inhibition was sought by a high-throughput overlay method as previously described with some modifications [12,33]. Different inoculum levels of the ten LAB cultures in MRS broth medium were tested in 24-well microplates (Sigma-Aldrich) with 500 μL of 1.5% MRS agar. Each culture suspension (1 μL) with different concentrations (103, 104, 105, 106, and 107 CFU/mL) was spotted on the surface center of each well. After anaerobic incubation for 48 h at 37 °C, the wells were covered with a 100 μL layer of 0.5% malt extract soft agar, which was then inoculated with the specific molds to a final concentration of 1.0 × 103 spores/mL (100 spores/well). The 24-well microplates were subsequently incubated at 25 °C for a maximum of 8 days. Control groups were prepared similarly to the wells inoculated with molds but without LAB cultures. Evaluation of results was conducted through visual assessment. The growth inhibition test was performed in triplicate for each mold strain.
4.4. Sensitivity to LAB in Yoghurt Serum
The sensitivity of these dairy-associated Penicillium strains towards different preparations of L. rhamnosus LRH01 and L. plantarum LP01 in yoghurt serum was assessed through evaluating the direct interactive effect of molds with the C-fermentates and CF-fermentates using an agar spot method. The sensitivities of the molds towards the volatiles generated by the two LAB cultures were evaluated in a “Plate-on-Plate” test system (Figure 1) without direct contact between the molds and the bacterial cultures [14].
A transparent yoghurt surrogate, yoghurt serum, was used as in this assay and prepared using centrifugation (4400× g, 30 min, 4 °C), followed by filtration through a 0.22 μm pore size filter for sterilization (Syringe Filter Q-Max, Frisenette ApS, Knebel, Denmark). To obtain LAB C-fermentates, the yoghurt serum was inoculated with L. rhamnosus LRH01 and L. plantarum LP01 (107 CFU/mL) in 250 mL Duran BlueCap bottles, respectively, and then fermented at 37 °C for 48 h. CF-fermentates were prepared using centrifugation (4400× g for 20 min at 4 °C), followed by filtration (0.45 μm pore size filter, Syringe Filter Q-Max, Frisenette ApS, Knebel, Denmark). Un-inoculated yoghurt serum stored at 37 °C for 48 h served as a control group.
4.4.1. Interaction with C-Fermentates
To prepare the agar plates (1% agar), the C-fermentates of L. rhamnosus LRH01 and L. plantarum LP01, as well as the control group (prepared as described above), were warmed in a 48 °C water bath. These samples were then mixed with melted, tempered agar and subsequently poured onto the plates. Sensitivity towards the C-fermentates was assessed by spotting 10 μL of each spore suspension (1.0 × 104 spores/mL) in triplicate on the C-fermentates agar plates. The agar plates prepared by mixing un-inoculated MRS broth with agar and inoculated with each mold served as the control groups. Multispectral images of the plates after incubation for 5 days at 25 °C were captured as described in Section 4.2. The MATLAB 2018b software (MathWorks, Inc., Natick, MA, USA) was utilized to quantify mold growth based on colony size (total number of pixels). The Inhibitory Effect (%) was calculated using the following formula:
where P indicates the total number of pixels of each colony in either control or sample groups.
4.4.2. Interaction with CF-Fermentates
The CF-fermentate agar plates (1% agar) were prepared following the method described for the preparation of the C-fermentate agar plates. The sensitivity of molds towards the CF-fermentates was calculated following the procedure outlined in Section 4.4.1.
4.4.3. Contribution of Volatiles to the Antifungal Activity
A yoghurt agar plate was inoculated with 10 μL of each mold spore suspension at 1.0 × 104 spores/mL (100 spores/spot) in triplicate. The LAB C-fermentate agar plate (prepared as described above) was positioned upside down on the yoghurt agar plate, and the two plates were securely sealed together using parafilm. The inhibitory effect was assessed after incubation for 5 days at 25 °C following the procedure outlined in Section 4.4.1.
4.5. Manganese Depletion Test
Commercial plain yoghurt was inoculated with L. plantarum LP01 and L. rhamnosus LRH01, reaching a final concentration of 107 CFU/mL for each culture. The inoculated yoghurt was then divided into four flasks, to which different concentrations of manganese (0.001 mM, 0.01 mM, and 0.1 mM) were added. A control group containing yoghurt without any LAB cultures or manganese was also included. Yoghurt agar plates (1% agar) were prepared by mixing the yoghurt samples with melted, tempered agar. Subsequently, 10 μL of a spore suspension containing each of the five Penicillium strains at a concentration of 1.0 × 104 spores/mL (100 spores/spot) were spotted in triplicate on these yoghurt agar plates. After a 5-day incubation period at 25 °C, multispectral images of the yoghurt agar plates with the spotted molds were captured using a Videometer Lab2. The quantification of mold growth was performed following the procedure described in Section 4.4.1.
4.6. A Challenge Test-Yoghurt Production and Biopreservation
4.6.1. Yoghurt Production
Yoghurt production was conducted by Arla Foods (Viby, Denmark) as follows: milk was heated at 85 °C for 30 min first, then rapidly cooled down to 43 °C. In the negative control group, only the starter culture was added into the milk; in the case of experimental groups, both starter culture and bioprotective cultures (107 CFU/mL, L. rhamnosus LRH01 and L. plantarum LP01) were added into the milk; in the positive control groups, instead of the tested bioprotective cultures, LR4PD (a commercial culture Lyofast composed of L. rhamnosus strains) was used as the positive culture and added into the milk. Then the milk samples were fermented at 43 °C until the pH reached 4.5 ± 0.05. After homogenization, the yoghurt samples were cooled down for 20 min to around 22 °C, and then stored at 4 °C. The following day, the yoghurt samples were taken for analysis.
4.6.2. Yoghurt Contamination and Biopreservation Test
The test was carried out using 6-well microplates [34,35]. The yoghurt sample prepared with L. plantarum LP01 or L. rhamnosus LRH01, respectively, was distributed into each well of the 6-well microplates in triplicate. Then 10 μL of spore suspension (1.0 × 103 spores/mL) of each mold was spotted on the center of each well. Results were determined by visually evaluating mold growth after incubation for up to 40 days at 7 °C compared with the negative control groups. The results were expressed as the number of days to visible mold growth.
4.7. Statistical Analyses
The results obtained in this study were presented as the mean ± standard deviation (SD) of three replicates. Statistical analyses were conducted using GraphPad Prism 9.0.2 (GraphPad Software, Inc., San Diego, CA, USA). The data were subjected to one-way analysis of variance (ANOVA) analysis followed by Tukey’s multiple-comparison post hoc test to determine any significant differences. A significance level of p < 0.05 was used to declare statistical significance.
5. Conclusions
L. rhamnosus LRH01 and L. plantarum 01 exhibited potent antifungal activity at low levels against five common dairy-associated Penicillium strains in laboratory media, and were selected among other strains for further study. In yoghurt serum, the Penicillium strains were very sensitive to the cell-containing fermentates of the two cultures, but the removal of cells from fermentates resulted in a significant decrease in antifungal activity. The volatiles exerted even more moderate antifungal effects in this system. Manganese depletion was demonstrated to be a key inhibitory mechanism of the tested LAB cultures in a plain yoghurt matrix since the addition of manganese partly or fully restored the growth of the Penicillium strains. In simulated product challenge tests, where the strains were added together with the starter cultures, L. rhamnosus LRH01 displayed a strong inhibitory effect in yoghurt, indicating the potential for yoghurt biopreservation. The antifungal activity of L. plantarum 01 in yoghurt, on the other hand, was much weaker than observed previously in the laboratory media, emphasizing that the interaction between LAB and spoilage fungi is impacted by a wide range of factors and care should therefore be taken to understand the inhibitory mechanisms in different settings.
Author Contributions
Conceptualization, C.S.; methodology and investigation: C.S., S.K.; writing-original draft preparation, C.S., writing-review and editing, S.K.; visualization, C.S.; supervision, S.K.; funding acquisition, S.K. All authors have read and agreed to the published version of the manuscript.
Funding
This work was financially supported by Project “Antifungal Dairy Product Bioprotection” financed by the Danish Dairy Research Foundation; Faculty of Science, University of Copenhagen; Natural Science Foundation of Jiangsu Province (Grant no. BK20220522), and Ce Shi thanks to the China Scholarship Council (Grant no. 201706170083) and the Startup Foundation of Jiangsu University for Senior Talents (Grant no. 5501360017).
Institutional Review Board Statement
Not applicable.
Informed Consent Statement
Not applicable.
Data Availability Statement
The data presented in this study are available on request from the corresponding authors.
Acknowledgments
We gratefully acknowledge SACCO S.r.l (Italy) for providing the bioprotective cultures and Anders Hauge Okholm (Arla Foods, Denmark) for yoghurt production using the selected bioprotective LAB cultures. We also sincerely thank F. W. J. van der Berg (Department of Food Science, University of Copenhagen, Denmark) for help with the analysis of the Videometer data using MATLAB 2018b software (MathWorks, inc., Natick, MA, USA).
Conflicts of Interest
The authors declare no conflict of interest.
References
- Garnier, L.; Valence, F.; Mounier, J. Diversity and Control of Spoilage Fungi in Dairy Products: An Update. Microorganisms 2017, 5, 42. [Google Scholar] [CrossRef]
- Pitt, J.I.; Hocking, A.D. Fungi and Food Spoilage; Springer: New York, NY, USA, 2009; ISBN 9780387922065. [Google Scholar]
- Pitt, J.I.; Hocking, A.D.; Pitt, J.I.; Hocking, A.D. Spoilage of Stored, Processed and Preserved Foods. In Fungi and Food Spoilage; Springer: New York, NY, USA, 1997; pp. 489–507. [Google Scholar]
- Buehler, A.J.; Evanowski, R.L.; Martin, N.H.; Boor, K.J.; Wiedmann, M. Internal Transcribed Spacer (ITS) Sequencing Reveals Considerable Fungal Diversity in Dairy Products. J. Dairy Sci. 2017, 100, 8814–8825. [Google Scholar] [CrossRef] [PubMed]
- Novais, C.; Molina, A.K.; Abreu, R.M.V.; Santo-Buelga, C.; Ferreira, I.C.F.R.; Pereira, C.; Barros, L. Natural Food Colorants and Preservatives: A Review, a Demand, and a Challenge. J. Agric. Food Chem. 2022, 70, 2789–2805. [Google Scholar] [CrossRef] [PubMed]
- Shi, C.; Maktabdar, M. Lactic Acid Bacteria as Biopreservation Against Spoilage Molds in Dairy Products—A Review. Front. Microbiol. 2022, 12, 819684. [Google Scholar] [CrossRef] [PubMed]
- Farag, M.A.; Saleh, H.A.; El Ahmady, S.; Elmassry, M.M. Dissecting Yogurt: The Impact of Milk Types, Probiotics, and Selected Additives on Yogurt Quality. Food Rev. Int. 2022, 38, 643–650. [Google Scholar] [CrossRef]
- Center for Food Safety and Applied Nutrition Food Additives & Ingredients—Food Additive Status List. Available online: http://www.fda.gov/food/ingredientspackaginglabeling/foodadditivesingredients/ucm091048.htm (accessed on 26 September 2023).
- Li, Q.Q.; Zeng, X.Q.; Fu, H.L.; Wang, X.M.; Guo, X.J.; Wang, M. Lactiplantibacillus plantarum: A Comprehensive Review of its Antifungal and Anti-Mycotoxic Effects. Trends Food Sci. Technol. 2023, 136, 224–238. [Google Scholar] [CrossRef]
- Stefańska, I.; Kwiecień, E.; Jóźwiak-Piasecka, K.; Garbowska, M.; Binek, M.; Rzewuska, M. Antimicrobial Susceptibility of Lactic Acid Bacteria Strains of Potential Use as Feed Additives—The Basic Safety and Usefulness Criterion. Front. Vet. Sci. 2021, 8, 687071. [Google Scholar] [CrossRef]
- Xu, R.; Sa, R.; Jia, J.; Li, L.; Wang, X.; Liu, G. Screening of Antifungal Lactic Acid Bacteria as Bioprotective Cultures in Yogurt and a Whey Beverage. J. Food Prot. 2021, 84, 953–961. [Google Scholar] [CrossRef]
- Luana, V.S.; Raiane, R.S.; Andressa, F.; Andressa, F.; Evandro, M.; Cinzia, C.; Cinzia, L.R.; Antonio, F.C. Evaluation of Antifungal Activity of Lactic Acid Bacteria against Fungi in Simulated Cheese Matrix. LWT 2023, 182, 114773. [Google Scholar]
- Garnier, L.; Mounier, J.; Lê, S.; Pawtowski, A.; Pinon, N.; Camier, B.; Chatel, M.; Garric, G.; Thierry, A.; Coton, E.; et al. Development of Antifungal Ingredients for Dairy Products: From in vitro Screening to Pilot Scale Application. Food Microbiol. 2019, 81, 97–107. [Google Scholar] [CrossRef]
- Aunsbjerg, S.D.; Honoré, A.H.; Marcussen, J.; Ebrahimi, P.; Vogensen, F.K.; Benfeldt, C.; Skov, T.; Knøchel, S. Contribution of Volatiles to the Antifungal Effect of Lactobacillus Paracasei in Defined Medium and Yogurt. Int. J. Food Microbiol. 2015, 194, 46–53. [Google Scholar] [CrossRef] [PubMed]
- Siedler, S.; Balti, R.; Neves, A.R. Bioprotective Mechanisms of Lactic Acid Bacteria against Fungal Spoilage of Food. Curr. Opin. Biotechnol. 2019, 56, 138–146. [Google Scholar] [CrossRef] [PubMed]
- Siedler, S.; Rau, M.H.; Bidstrup, S.; Vento, J.M.; Aunsbjerg, S.D.; Bosma, E.F.; Mcnair, L.M.; Beisel, C.L.; Neves, A.R. Competitive Exclusion Is a Major Bioprotective Mechanism of Lactobacilli against Fungal Spoilage in Fermented Milk Products. Appl. Environ. Microbiol. 2020, 86, e02312–e02319. [Google Scholar] [CrossRef]
- Shi, C.; Knøchel, S. Sensitivity of Molds from Spoiled Dairy Products Towards Bioprotective Lactic Acid Bacteria Cultures. Front. Microbiol. 2021, 12, 631730. [Google Scholar] [CrossRef]
- Liang, N.; Zhao, Z.; Curtis, J.M.; Gänzle, M.G. Antifungal Cultures and Metabolites of Lactic Acid Bacteria for Use in Dairy Fermentations. Int. J. Food Microbiol. 2022, 383, 109938. [Google Scholar] [CrossRef]
- Abouloifa, H.; Gaamouche, S.; Rokni, Y.; Hasnaoui, I.; Bellaouchi, R.; Ghabbour, N.; Karboune, S.; Brasca, M.; D’Hallewin, G.; Ben Salah, R.; et al. Antifungal Activity of Probiotic Lactobacillus Strains Isolated from Natural Fermented Green Olives and Their Application as Food Bio-Preservative. Biol. Control 2021, 152, 104450. [Google Scholar] [CrossRef]
- Guimarães, A.; Venancio, A.; Abrunhosa, L. Antifungal Effect of Organic Acids from Lactic Acid Bacteria on Penicillium nordicum. Food Addit. Contam. Part A Chem. Anal. Control Expo. Risk Assess. 2018, 35, 1803–1818. [Google Scholar] [CrossRef] [PubMed]
- Leyva Salas, M.; Mounier, J.; Valence, F.; Coton, M.; Thierry, A.; Coton, E. Antifungal Microbial Agents for Food Biopreservation—A Review. Microorganisms 2017, 5, 37. [Google Scholar] [CrossRef]
- Leila, B.F.; Neyssene, A.; Raquel, T.; Carlos, L.; Giuseppe, M.; Ferid, A. Correlation Between Metabolites of Lactic Acid Bacteria Isolated from Dairy Traditional Fermented Tunisian Products and Antifungal and Antioxidant Activities. J. Appl. Microbiol. 2022, 133, 3069–3082. [Google Scholar]
- Mani-López, E.; Arrioja-Bretón, D.; López-Malo, A. The Impacts of Antimicrobial and Antifungal Activity of Cell-Free Supernatants from Lactic Acid Bacteria in vitro and Foods. Compr. Rev. Food Sci. Food Saf. 2022, 21, 604–641. [Google Scholar] [CrossRef]
- Luz, C.; D’Opazo, V.; Quiles, J.M.; Romano, R.; Mañes, J.; Meca, G. Biopreservation of Tomatoes Using Fermented Media by Lactic Acid Bacteria. LWT 2020, 130, 109618. [Google Scholar] [CrossRef]
- Shi, C.; Knøchel, S. Susceptibility of Dairy Associated Molds towards Microbial Metabolites with Focus on the Response to Diacetyl. Food Control 2021, 121, 107573. [Google Scholar] [CrossRef]
- Bin, L.; Zhirong, W.; Gang, Y.; Shan, H.; Shenglan, L.; Kewei, C.; Muying, D.; Zsolt, Z.; Ferenc, H.; Jianquan, K. Biocontrol Potential of 1-Pentanal Emitted from Lactic Acid Bacteria Strains against Aspergillus Flavus in Red Pepper (Capsicum Annuum L.). Food Control 2022, 142, 109261. [Google Scholar]
- Schmidt, S.B.; Jensen, P.E.; Husted, S. Manganese Deficiency in Plants: The Impact on Photosystem II. Trends Plant Sci. 2016, 21, 622–632. [Google Scholar] [CrossRef] [PubMed]
- Jensen, A.N.; Jensen, L.T. Manganese Transport, Trafficking and Function in Invertebrates. In Manganese in Health and Disease; Issues in Toxicology; Royal Society of Chemistry: Cambridge, UK, 2014; pp. 1–33. [Google Scholar]
- Bosma, E.F.; Rau, M.H.; van Gijtenbeek, L.A.; Siedler, S. Regulation and Distinct Physiological Roles of Manganese in Bacteria. FEMS Microbiol. Rev. 2021, 45, fuab028. [Google Scholar] [CrossRef] [PubMed]
- Porcheron, G.; Garénaux, A.; Proulx, J.; Sabri, M.; Dozois, C.M. Iron, Copper, Zinc, and Manganese Transport and Regulation in Pathogenic Enterobacteria: Correlations between Strains, Site of Infection and the Relative Importance of the Different Metal Transport Systems for Virulence. Front. Cell Infect. Microbiol. 2013, 3, 90. [Google Scholar] [CrossRef]
- Tong, Y.; Wang, G.; Zhang, Q.; Tian, F.; Liu, X.; Zhao, J.; Zhang, H.; Chen, W. Systematic Understanding of the Potential Manganese-Adsorption Components of a Screened: Lactobacillus plantarum CCFM436. RSC Adv. 2016, 6, 102804–102813. [Google Scholar] [CrossRef]
- Ebrahimi, P.; van den Berg, F.; Aunsbjerg, S.D.; Honoré, A.; Benfeldt, C.; Jensen, H.M.; Engelsen, S.B. Quantitative Determination of Mold Growth and Inhibition by Multispectral Imaging. Food Control 2015, 55, 82–89. [Google Scholar] [CrossRef]
- Inglin, R.C.; Stevens, M.J.A.; Meile, L.; Lacroix, C.; Meile, L. High-Throughput Screening Assays for Antibacterial and Antifungal Activities of Lactobacillus Species. J. Microbiol. Methods 2015, 114, 26–29. [Google Scholar] [CrossRef]
- Ouiddir, M.; Bettache, G.; Leyva Salas, M.; Pawtowski, A.; Donot, C.; Brahimi, S.; Mabrouk, K.; Coton, E.; Mounier, J. Selection of Algerian Lactic Acid Bacteria for Use as Antifungal Bioprotective Cultures and Application in Dairy and Bakery Products. Food Microbiol. 2019, 82, 160–170. [Google Scholar] [CrossRef]
- Salas, M.L.; Thierry, A.; Lemaître, M.; Garric, G.; Harel-Oger, M.; Chatel, M.; Lê, S.; Mounier, J.; Valence, F.; Coton, E. Antifungal Activity of Lactic Acid Bacteria Combinations in Dairy Mimicking Models and Their Potential as Bioprotective Cultures in Pilot Scale Applications. Front. Microbiol. 2018, 9, 1787. [Google Scholar]
Disclaimer/Publisher’s Note: The statements, opinions and data contained in all publications are solely those of the individual author(s) and contributor(s) and not of MDPI and/or the editor(s). MDPI and/or the editor(s) disclaim responsibility for any injury to people or property resulting from any ideas, methods, instructions or products referred to in the content. |
© 2023 by the authors. Licensee MDPI, Basel, Switzerland. This article is an open access article distributed under the terms and conditions of the Creative Commons Attribution (CC BY) license (https://creativecommons.org/licenses/by/4.0/).